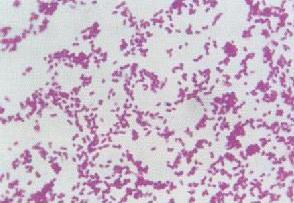
伊拉克細菌

背景
超級細菌(MRSA)出現了,人們開始懷疑抗生素時代是否即將終結。但來自青蛙的強力新型抗生素的發現卻明確昭示了人類和細菌的纏鬥尚遠未結束。
2010年8月27日(台北時間),據英國每日電訊報報導,阿聯大學的一個研究小組已經在青蛙皮膚中提取了100種新型抗生素,其中有些抗生素甚至能抵抗臭名昭著的超級細菌和“伊拉克細菌”。
研究
“伊拉克細菌”是對多種藥物產生耐藥性的鮑曼不動桿菌
“伊拉克細菌”是對多種藥物產生耐藥性的鮑曼不動桿菌“伊拉克細菌”是對多種藥物產生耐藥性的鮑曼不動桿菌。2010年8月,阿聯大學的最新研究顯示,一種從黃腿蛙皮膚分泌物中提取的物質可以殺死超級細菌,而貂皮蛙的皮膚分泌物能抵抗“伊拉克細菌”。
從青蛙皮膚中提抗生素可殺伊拉克細菌
青蛙在地球上已生活了3億年左右,有充分時間學習如何與各種環境共處,抵抗各種致病微生物。另外,青蛙經常生活在被污染的水道中,也因此造就了強大的抵抗病原體能力,其皮膚可成為優秀抗生素的來源。
儘管青蛙皮膚富含多種化學成分,能殺死細菌、病毒和真菌,但生存環境所致,它們皮膚分泌物中也同時含有大量對人體有毒的物質,有些抗菌成分也很容易受到血管中破壞酶的破壞。阿聯大學生化學家米歇爾·康隆領導的研究小組成功地從青蛙皮膚中分離出了這些抗菌物質,並找到了一種改良方法,減輕或消除了它們對人體的有害作用。
康隆團隊所用的改良方法是扭轉這些抗菌物質的分子結構,在增強其滅菌作用的同時減少其對人體細胞的毒性。他們還開發出不再受血液中破壞酶攻擊的扭轉結構藥物,使其在血管中的停留時間更長,對付感染也更加有效。
康隆表示,在向各種致病微生物宣戰的研究中,從青蛙皮膚分泌物中尋找抗生素,是一種不同尋常的思路。另闢蹊徑也就意味著這項工作相當艱難,研究人員甄選的皮膚分泌物來自6000多種青蛙,但至今(2010年)得到提純並確定化學結構的僅有200種,剩餘分泌物中或許還能挖掘出大量的“超級”抗生素。

